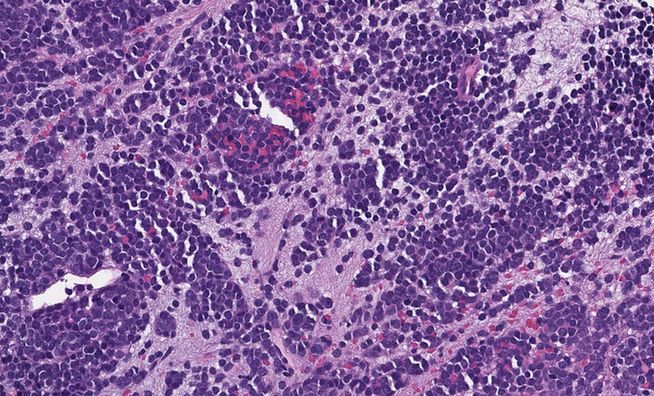

Megan
@megothelioma.bsky.social
120 followers
22 following
45 posts
Pathology Fellow. Always learning. #pathsky
Posts
Media
Videos
Starter Packs